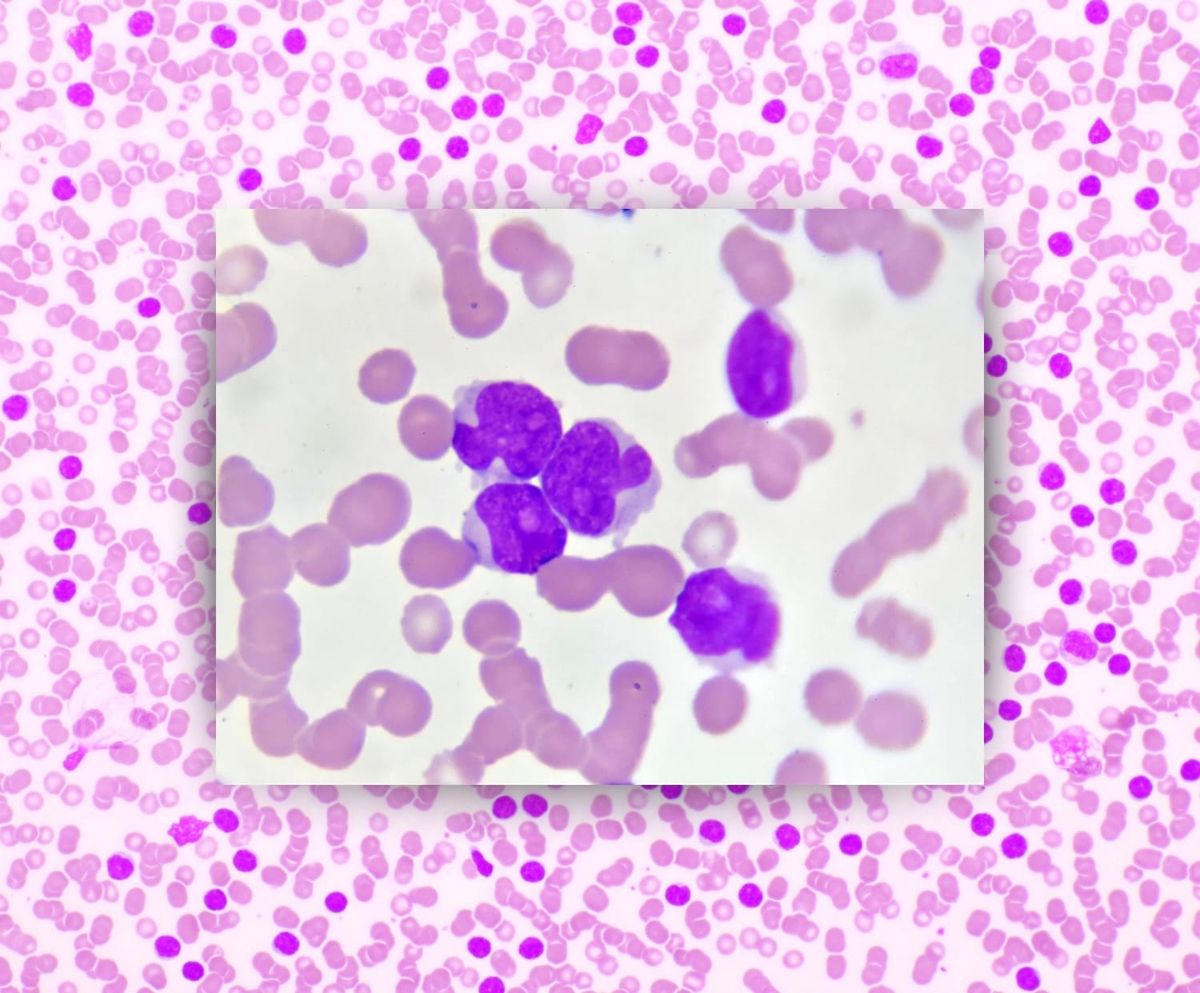
Leukemia 101

Leukemia 101
A gentle primer on the unique cancer we’re dealing with.
Before Michael’s diagnosis, my knowledge of Leukemia was a vague sense it was a type of cancer kids get. Turns out it is in fact the most common type of childhood cancer. Before December, I’d never met anyone diagnosed as an adult.
We clearly had a steep learning curve at the beginning of this journey. Googling our questions led only to nightmarish information we hadn’t asked for instead of what we actually wanted to know. We quickly learned to start on the website of a reputable cancer center and put our question in their search bar, or to go straight to medical journal sites to look for published, peer reviewed research papers.
One thing immediately apparent was how completely different pediatric Leukemia is from adult Leukemia. It may be the most common type of childhood cancer, but it slips pretty far down the list in adults, especially Acute Leukemia. The long term survival rate for kids with Leukemia is high and increasing all the time as new treatments and therapies emerge. For adults the story is a bit different, primarily because as we age there are other risk factors which come into play, like heart disease or diabetes, plus the general declining health of our bone marrow and its ability to make new stem cells.
I know we’re all coming from different places with knowledge of cancer, Leukemia specifically, so I wanted to put together a general, not-too-scary, casual guide of what is it and where Michael’s type of cancer fits in. Or doesn’t, because Michael is a unicorn of uniqueness!
There are two kinds of Leukemia, Chronic and Acute.
Chronic comes on slowly and can generally be treated slowly, often with an initial round of chemotherapy followed by a simple ‘wait and see’ approach or with oral medication. It’s often discovered incidentally, during an annual physical when a routine blood test is ordered, rather than because someone has specific symptoms that cause them to see a doctor. If you know an adult who has been living with Leukemia for a long time (years and years), it’s likely Chronic. Acute Leukemia is different, it lands like a bomb with rapid, aggressive damage. A patient may have sudden rash-like bruising, severe bone pain, extreme fatigue, or an infection that doesn’t get better, landing them in the ER or doctor’s office. Acute Leukemia is treated with more rapid, aggressive therapies to match how quickly it progresses.
Within these two kinds of Leukemia are two major subtypes, Myeloid (also called Myelogenous) and Lymphoblastic (also known as Lymphocytic. Hong Kong uses Myeloid and Lymphoblastic, so I’ll use those terms here). There are other minor subtypes, but we’ll focus on just those two. It’s possible to have Chronic Myeloid Leukemia (CML), Chronic Lymphoblastic Leukemia (CLL), Acute Myeloid Leukemia (AML), or Acute Lymphoblastic Leukemia (ALL).
Bone marrow produces stem cells which can become Myeloid or Lymphoid cells. Myeloid cells mature into adult blood cells like neutrophils or platelets which make up the rapid (or innate) response part of our immune system. Imagine Myeloid cells like little paramedics in a speeding ambulance, running to the scene of an incident, working quickly to fight infection or injury. Lymphoid cells mature into T-cells, B-cells, or “killer” cells which are the more targeted and complex (or adaptive) part of our immune system. When we get sick, Lymphoid cells can create antibodies which remember the illness and help us not get sick from that same illness again. They can also recognize what is supposed to be in our bodies and what shouldn’t be there, fighting off and killing foreign cells before the foreign cells can cause too much damage. If Myeloid cells are like paramedics in the field, Lymphoid cells might be more like a research and teaching hospital, studying disease and training doctors in specialities.
When our stem cells have matured into their final forms, they are released into our blood stream to keep us healthy and well, making space for new stem cells to start the process all over again in our bone marrow.
Leukemia (which comes from the Greek leukos meaning white and haima meaning blood) happens when one of the developing blood cells begin to multiply out of control before they can mature into the useful blood cells which keep us healthy. These immature cells, called blasts, can be Myeloid or Lyphoid and take over the space in your bone marrow, crowding out platelets and neutrophils and T-cells with immature cells. This can be a recipe for disaster if you are exposed to an illness or get badly injured. In Chronic Leukemia, as mentioned above, this happens slowly, often over the course of many years and may not show any symptoms for a long time. But in the Acute form of Leukemia, it is quite rapid — you can go from healthy to medical emergency within days or weeks.
Immediately before Michael was diagnosed, we were on a long European Christmas Market holiday. We travelled by train from one end of Europe to the other and then back again. Most days we walked 7 to 10 miles (11 to 16 kilometers). It was exhausting and exhilarating! In the middle of our trip we had a stop in Mainz, Germany to finally meet my long-time virtual friend Carolyne and her husband Chandler. I had “known” her for nearly fifteen years, starting from when I was living in Macau and she was living in South Korea and we were both blogging (and then Instagramming) our experiences abroad with (now fully grown) kids and dogs in tow. Our lives circled one another for all these years without touching in real life. When planning our European trip, we picked her city for a stop because enough was enough, it was time to meet up!
We got into Mainz quite late at night — our scheduled evening train switched tracks at the last moment, we watched it depart while still puzzling out the announcement in German. Face, meet palm. Thankfully there was still one more connecting train that evening. We were totally beat by the time we finally got to our hotel after a day of speed walking all over Berlin. We met up with Carolyne and Chandler extra early to make the most of our long awaited single day together. Chandler made us a superb breakfast before leaving for work, and then Carolyne took us on a six mile (10km) comprehensive historic walking tour of Mainz. It was an epic, personal view into a city we likely would never have known about had she not called it home for the last several years. Carolyne and I made up for nearly fifteen years of not being together in person, talking just as fast as we were walking.
The whole day Michael lagged slightly behind and I figured it was just to give us space to jump around rapidly in conversation. As the sun was setting and we enjoyed an obligatory mug of local glühwein, Michael looked especially exhausted. He said he felt hot and a little unwell, with a dry, unproductive cough and a feeling like he couldn’t get a deep enough breath. We attributed it to the rapid pace of the trip, getting in quite late the night before, and spending a lot of time outdoors in the cold which often triggers an asthma attack.
Instead of an outdoor dinner standing up at the Mainz Christmas markets, we opted to take Carolyne up on her offer to go back to her place for homemade chili. Back in her cozy home, Michael uncharacteristically stretched out on the sofa, immediately falling into deep sleep. I remember thinking it was a testament to my friend’s warm hospitality that he felt comfortable enough to just snooze so casually in the home of someone he’d just met. Carolyne and I chatted for several more hours before finally tearing ourselves apart, Michael and I heading back to our hotel for showers and sleep before catching our early morning train to Bruges, Belgium. It was a memorable day because I finally got to hang out in real life with Carolyne. But also because this is when we believe the Acute Leukemia first made itself known. What a gift it is to have something so spectacular and precious to offset the grim and frightening!

When immature blast cells reproduce out of control and take up all the space in bone marrow, your red blood count goes way down. This causes anemia, which can manifest in weakness, fatigue, and shortness of breath. White blood cells usually increase when you’re sick because they are trying to fight off whatever is attacking you, and that often produces a raised temperature at night, which might make you sweaty in your sleep. For the rest of our trip across Europe, Michael continued to feel fatigued with a dry, shallow cough and the feeling of not getting enough oxygen no matter how deep a breath he took. He did several rapid Covid, influenza, and RSV tests and all were negative, and though he felt feverish he didn’t have a fever. While outdoor temperatures hovered at freezing, every hotel room we stayed in was overly hot with windows which didn’t open. Michael’s night sweats were easy to explain away due to the heat in the rooms. Our whole trip I was also sweating all night, so it wasn’t especially alarming. The exhaustion wasn’t an immediate red flag as we were on the go, go, go constantly, climbing bell towers and fortress walls, running for trains dragging luggage, sampling lots of rich, heavy food. It’s only in looking back we can see how the signs were all obvious.
When we took Michael to the Emergency Room on December 23rd, his White Blood Count (WBC) was at 89. Twenty-four hours later it had risen to 104. Normal is between 4.5 and 11. He had no Neutrophils, those little paramedics that zip to the site of injury or illness to provide an immediate defense against infection. The first blood test they did in the ER (A&E) showed 70% of his total blood cells were blasts, the immature cancer cells rapidly reproducing in the bone marrow and crowding out mature, healthy blood cells. It was enough to diagnose Acute Leukemia, but they needed to run other tests including a bone marrow aspiration to get the exact subtype (Myeloid or Lymphoblastic) to know the best way to treat it.
By January 1st when they had a definitive diagnosis and were ready to begin treatment, the percentage of blast cells in Michael’s blood had risen to 95%. With Chronic Leukemia blasts are typically at about 10-20%. Acute Leukemia is generally diagnosed when blasts are above 20%. Knowing Michael’s percentage had risen from 70% to 95% in just one week is utterly nauseating, seeing how close Michael was to complete disaster. Once again we only understand that by looking back. At the time we were standing defenseless in the blast of a fire hose of terrifying information.
Treatment for Acute Leukemia is different depending on the subtype. On December 24th when they first told us he had Acute Leukemia, they said they needed more testing to determine if it was Myeloid or Lymphoblastic. One doctor told him it was probably AML, while a day later a nurse said his file mentioned ALL. We asked for confirmation every single day, but were told the results needed to be reviewed more carefully. We’d been told time was of the essence. They’d bluntly informed us that without any treatment, life expectancy was about one to three months. We were keenly aware Michael had begun showing symptoms at least three weeks prior, so we were worried how Michael’s results, and therefore his treatment, were taking too long.
When the results were finalized and had been run through a whole committee of hematology doctors across Hong Kong for confirmation, we were shocked all over again. We’d been led to believe it was an either/or situation, either AML or ALL. We had no idea it was possible to have a mixture of both. Though there is mention of “ambiguous origin” Leukemia in medical journals going back to the 1980’s, it’s only been officially classified as Mixed Phenotype Acute Leukemia (MPAL) by the WHO starting in 2008. Acute Leukemia in adults is already quite rare, with less than 1% of new cancers each year being either ALL or AML. Of those, Mixed Phenotype makes up less than 4% of all Acute Leukemia cases. It’s so rare there are almost no published studies on it, there is no single agreed upon best course of treatment for it. Looking back once again, it makes sense that they quadruple checked all of Michael’s test results since most large cancer hospitals may only see one to two new cases in a year.
I passionately love anything that is unique and special, weird and unusual. When we were informed it was MPAL, I told Michael I already love him, I already married him, he didn’t need to try and get my attention with this rare unicorn of cancers! But of course that wasn’t the end of it. Michael is committed to impressing me with being one of a kind, or as close as he can get.
The hospital wanted to run one more test to determine if there was a genetic mutation called the Philadelphia Chromosome (or BCR::ABL1, a far less catchy name). First noted in 1960 in the city of Philadelphia, Pennsylvania in the United States, the mutation is when part of chromosomes 9 and 22 swap places. This creates a new gene with an active protein stuck in the ‘on’ position, reproducing white blood cells at an uncontrollable rate. This makes treating Leukemia even more challenging and complicated because the mutation is in your DNA. And while we prayed this would be negative, they delivered a positive diagnosis and his first dose of a TKI at the same time on New Year’s Day.
I wrote about the medication Michael is taking a while ago, which you can read here. Tyrosine Kinase Inhibitors work to suppress, or inhibit, that protein stuck in the ‘on’ position. How long he will need to take it is something no one can answer right now. His team of doctors are committed to treating Michael step-by-step with only general points instead of laying out a full, intricate plan to follow because as we learn every single day, things change before we ever get a chance to get used to them. It makes sense, but it doesn’t make it less frustrating. We know we are in good hands.
An upcoming post will share the overall plan (as it stands currently!) along with where Michael is in the treatment. Things are currently moving at a rapid pace after a whole lot of nothing for many weeks, keeping us on our toes and requiring a significant amount of courage. Thank you for the support, encouragement, prayers, and kind words. We are incredibly grateful. More on the way shortly!

Thank you for reading! If you’re interested in supporting us with a one time financial contribution, consider giving any amount through Buy Me A Coffee!



